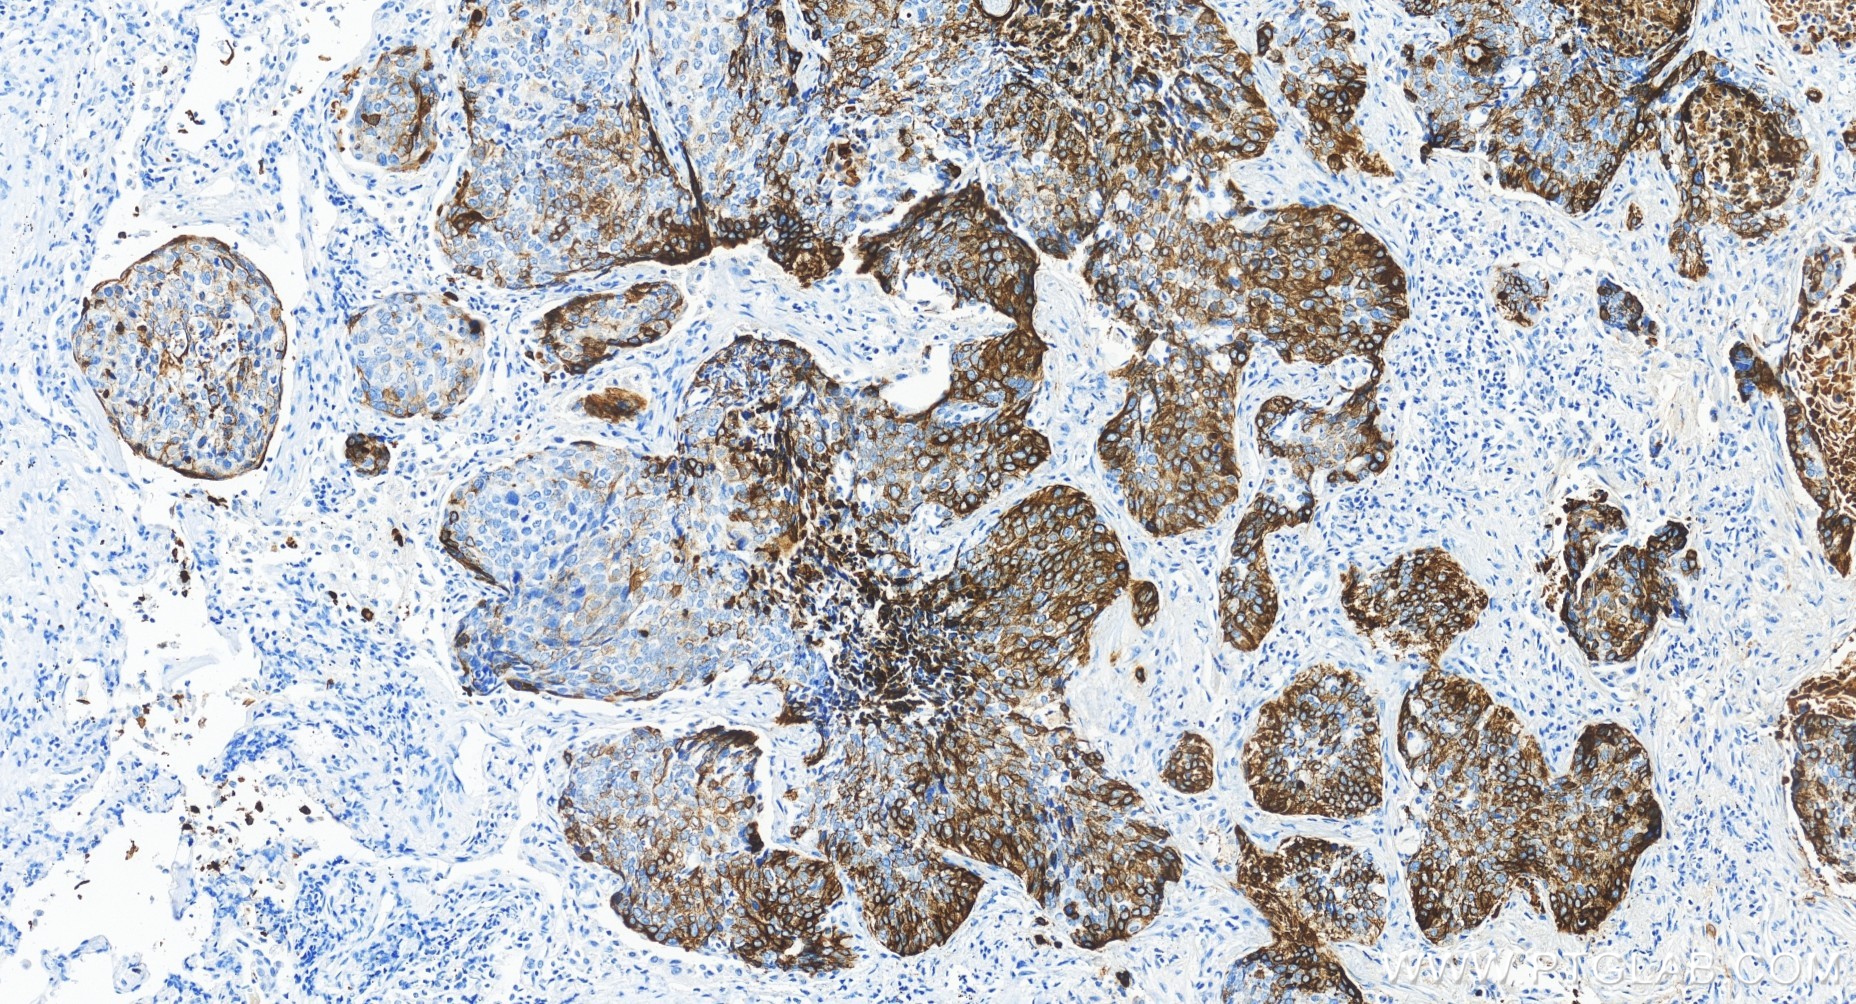

验证数据展示
产品信息
83379-1-PBS targets Cytokeratin 14 in WB, IHC, IF-P, Indirect ELISA applications and shows reactivity with human, mouse, rat samples.
| 经测试应用 | WB, IHC, IF-P, Indirect ELISA Application Description |
| 经测试反应性 | human, mouse, rat |
| 免疫原 |
CatNo: Ag0188 Product name: Recombinant human KRT14 protein Source: e coli.-derived, PGEX-4T Tag: GST Domain: 262-472 aa of BC002690 Sequence: GQVGGDVNVEMDAAPGVDLSRILNEMRDQYEKMAEKNRKDAEEWFFTKTEELNREVATNSELVQSGKSEISELRRTMQNLEIELQSQLSMKASLENSLEETKGRYCMQLAQIQEMIGSVEEQLAQLRCEMEQQNQEYKILLDVKTRLEQEIATYRRLLEGEDAHLSSSQFSSGSQSSRDVTSSSRQIRTKVMDVHDGKVVSTHEQVLRTKN 种属同源性预测 |
| 宿主/亚型 | Rabbit / IgG |
| 抗体类别 | Recombinant |
| 产品类型 | Antibody |
| 全称 | keratin 14 |
| 别名 | KRT14, 1H22, CK 14, CK14, CK-14 |
| 计算分子量 | 472 aa, 52 kDa |
| 观测分子量 | 52 kDa |
| GenBank蛋白编号 | BC002690 |
| 基因名称 | Cytokeratin 14 |
| Gene ID (NCBI) | 3861 |
| 偶联类型 | Unconjugated |
| 形式 | Liquid |
| 纯化方式 | Protein A purfication |
| UNIPROT ID | P02533 |
| 储存缓冲液 | PBS only, pH 7.3. |
| 储存条件 | Store at -80°C. The product is shipped with ice packs. Upon receipt, store it immediately at -80°C |
背景介绍
Cytokeratin 14, one of about 20 different cytokeratin isotypes of human cells, is the intermediate filament protein characteristic of epithelial cells. Cytokeratin 14 is expressed in the basal compartment of all stratified squamous epithelia. In various kinds of human tumors, the appearance and increasing expression of Cytokeratin 14 were strikingly associated with higher grade and stage of carcinoma, with varying degrees of unfavorable prognosis. In lung squamous cell carcinoma(LSCC), Cytokeratin 14 was expressed in the tumor cell nests showing stromal invasion with fibrosis and lymph node metastases, indicating that Cytokeratin 14 involved in proliferation and metastasis of LSCC. Cytokeratin 14 expression is sometimes used in diagnosis of myoepithelioma1 and intraductal vs. invasive ductal carcinoma of the breast.